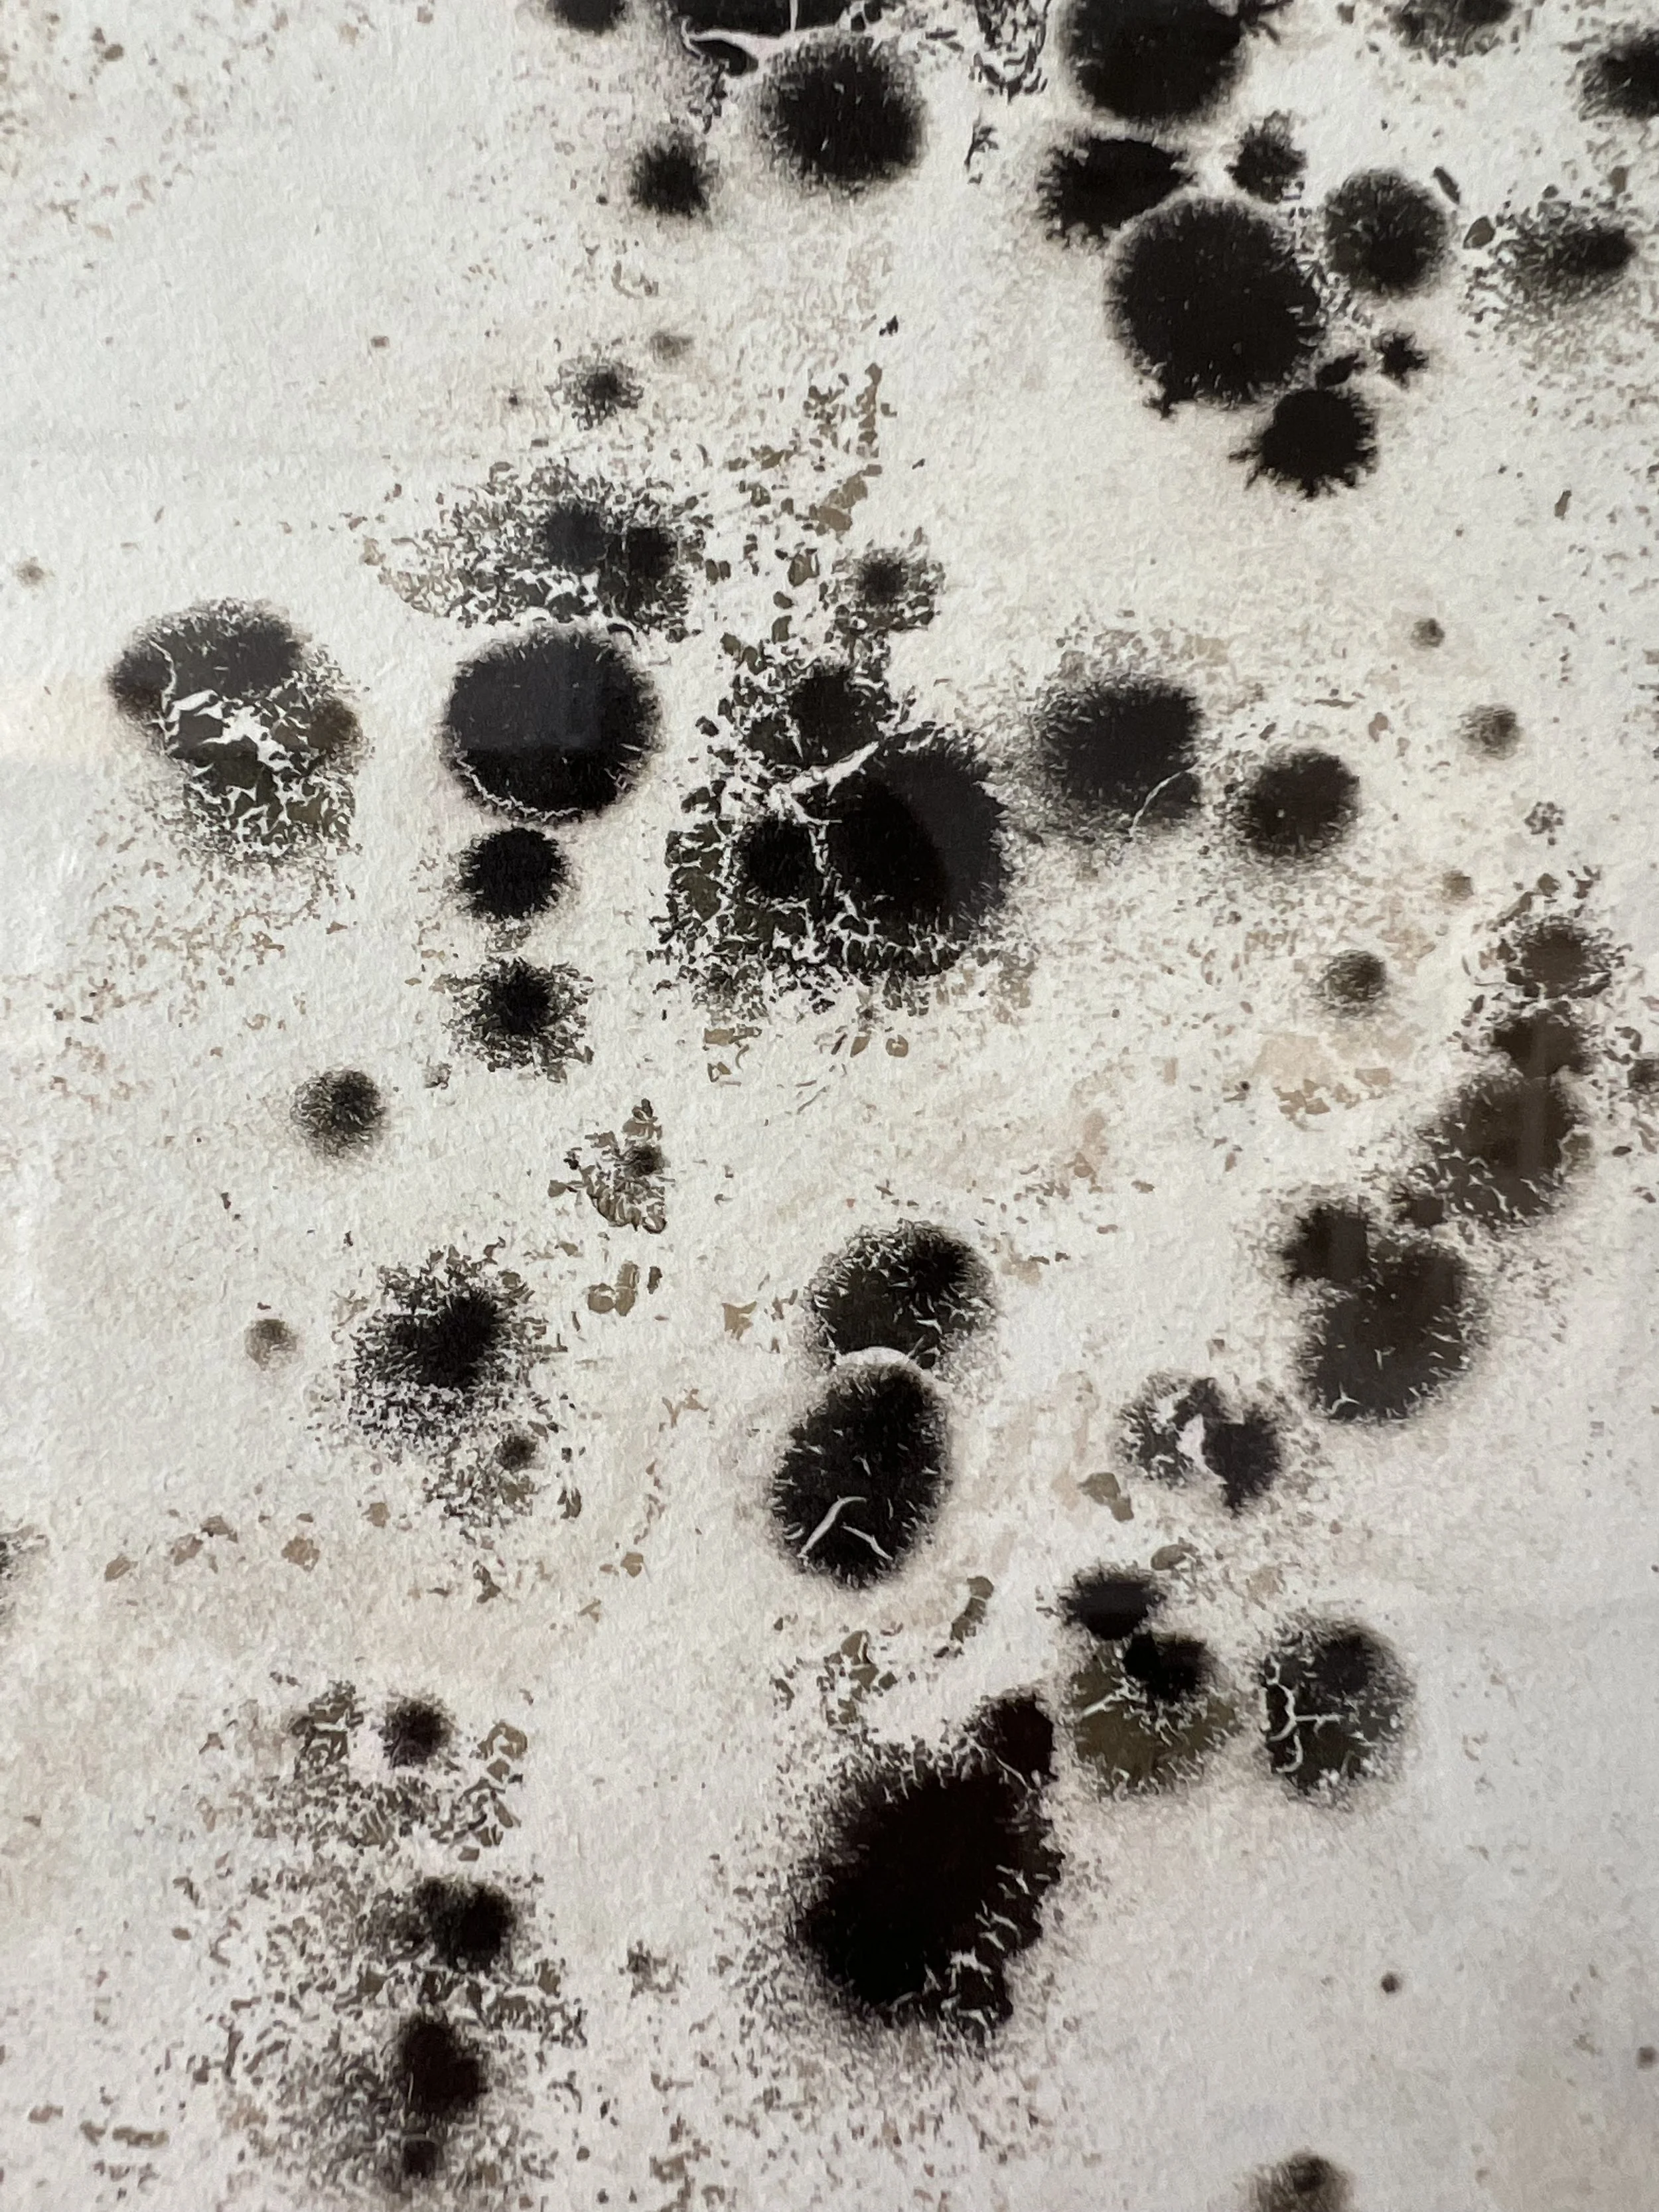
IMG_3986.JPG

"Del apolíneo soporte pictórico tradicional al impulsivo baile dionisíaco"

"Del apolíneo soporte pictórico tradicional al impulsivo baile dionisíaco"
550,00 €
TUSET 2017 - 2022
35 x 27 cm.
Ejercicio informalista.
Experimentación pictórica con tinta de bolígrafo corriente y agua de mar.
(Trabajamos con GALIART, empresa especializada en el enmarcado profesional de obras de arte bajo pedido)
Incluye certificado de autenticidad firmado por el artista y sellado por la galería. Precio por c/u.
VENDIDO SOLD
